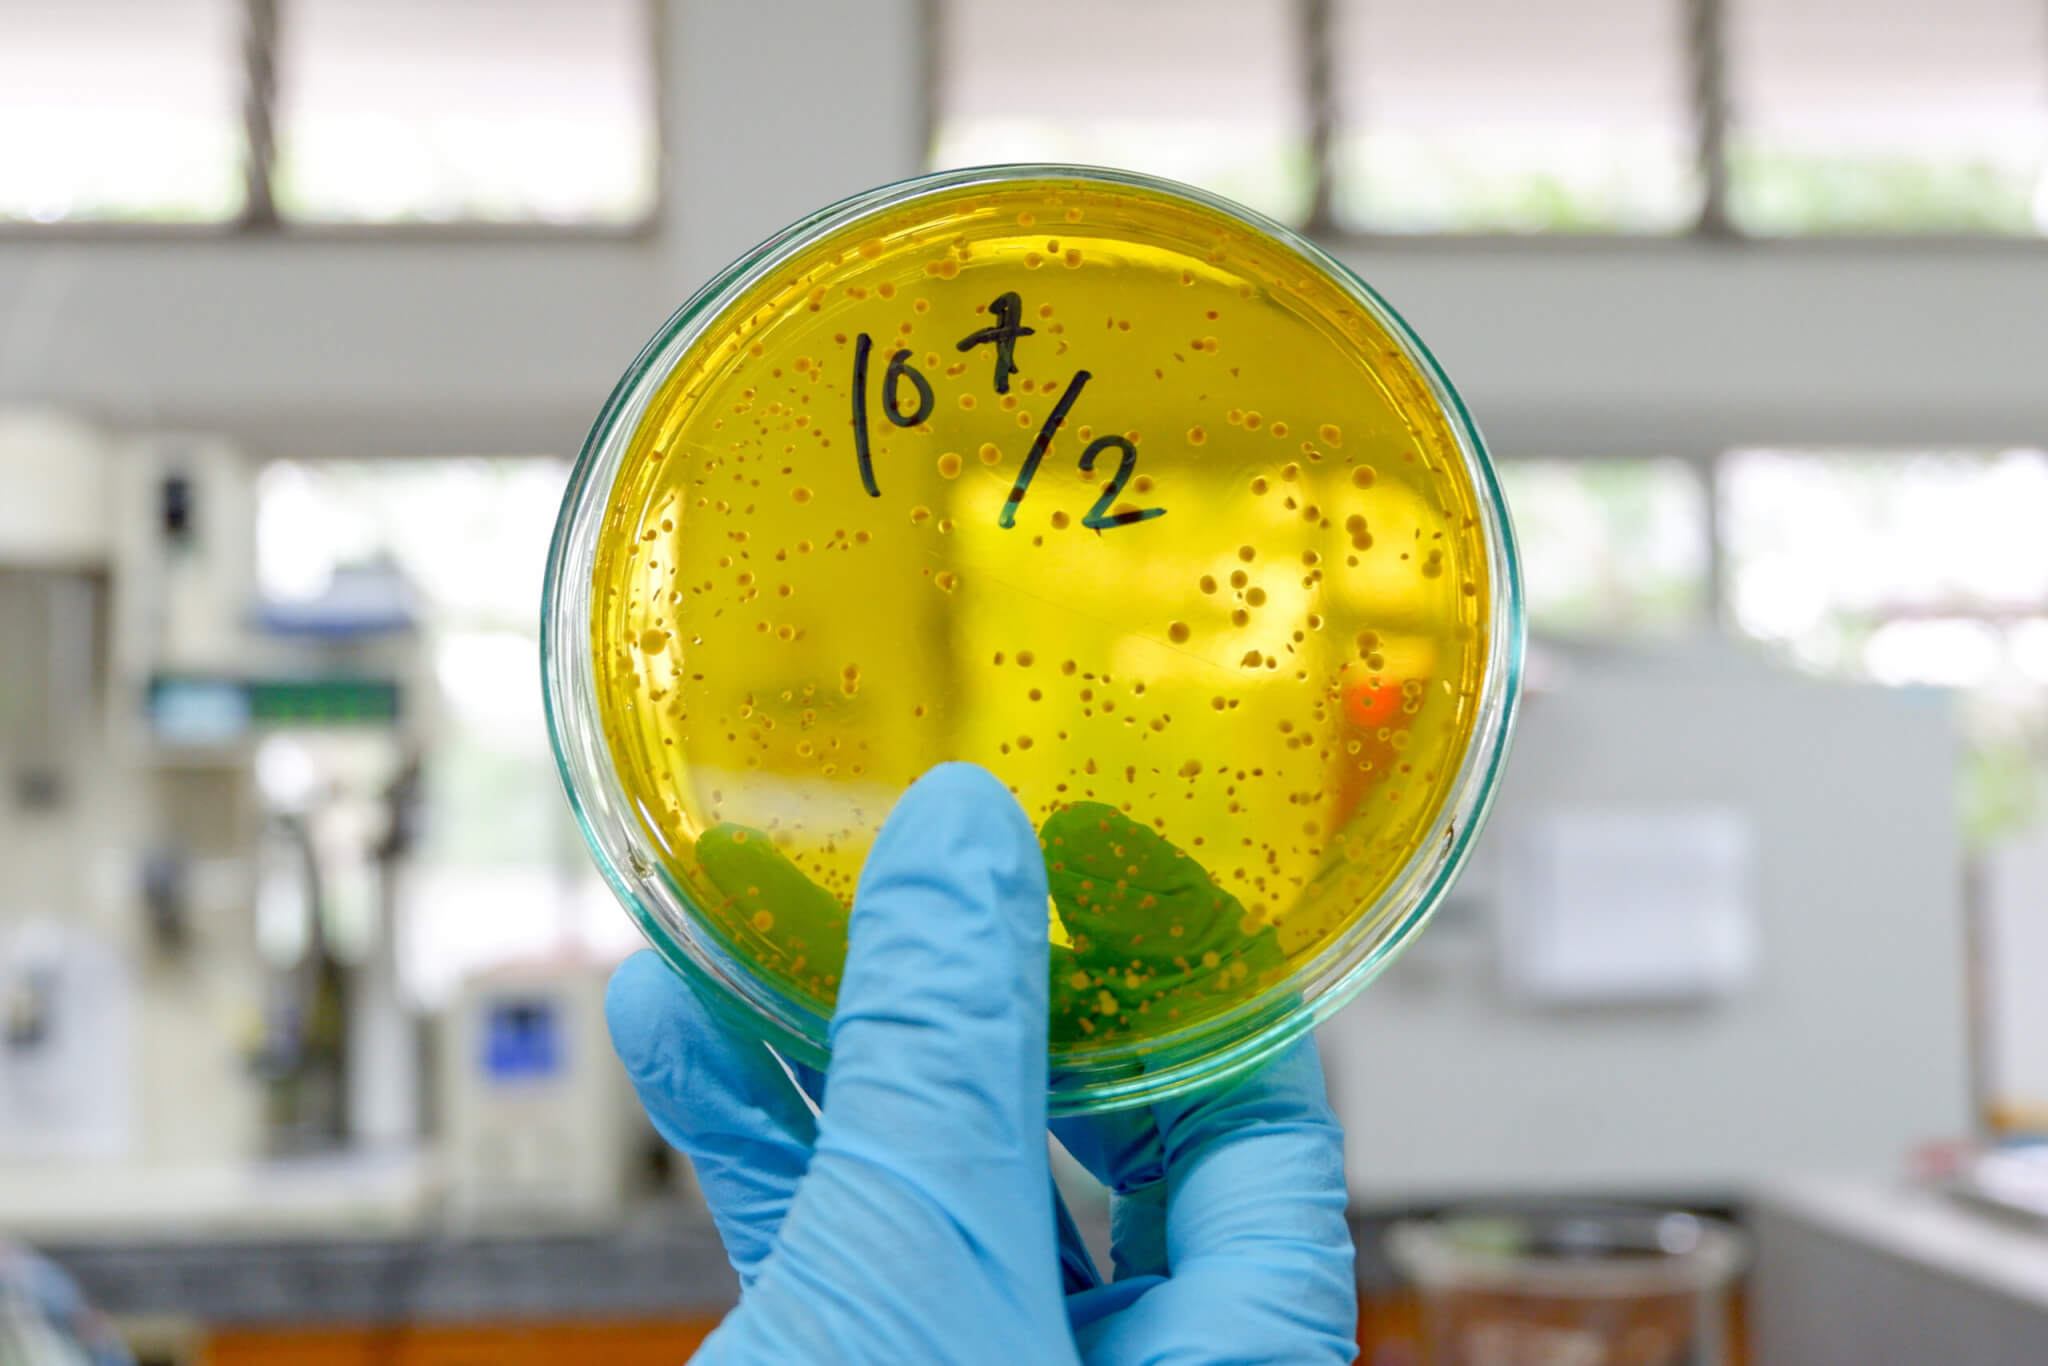
Microbiologist counts Lactobacillus rhamnosus colony in dish.

(© Feng Yu - stock.adobe.com)
BOSTON — An intriguing new study proposes that the intake of a specific probiotic could aid in thwarting the memory and thinking deterioration often associated with aging. This groundbreaking research has the potential to clear the path for innovative, non-invasive treatments using the gut microbiome to combat cognitive decline in the aging population.
As people get older, their gut microbiome (the community of microbes living in the digestive tract) changes, and their cognitive abilities (like thinking and remembering) often decrease. This study looked at the gut microbiomes of middle-aged and older adults, some of whom had mild cognitive impairment (MCI) – which means they had minor problems with things like memory or decision-making – and compared them with adults of the same age who didn’t have any brain-related health problems. Probiotics are like “good” bacteria that can help with digestion and overall health. In this study, the scientists wanted to know if these probiotics could also improve mental health and protect the brain as it ages.
Participants with MCI who took the probiotic Lactobacillus rhamnosus GG (LGG) for three months saw an increase in their cognitive scores, a change researchers linked to gut microbiome alterations.
“Many studies focus on severe forms of cognitive diseases such as Alzheimer’s and dementia, but these conditions are more advanced, making them significantly harder to reverse or treat,” says Mashael Aljumaah, a microbiology doctoral candidate at the University of North Carolina at Chapel Hill and North Carolina State University, in a media release.
This research instead turned its focus to mild cognitive impairment, which can manifest as problems with memory, language, or judgment.
“Interventions at this stage of cognitive impairment could slow down or prevent the progression to more severe forms of dementia,” Aljumaah adds.
How probiotics are linked with cognitive decline
The double-blind, randomized clinical trial included 169 participants who were between 52 and 75 years old. They were split into two groups: one took the probiotic and the other took a placebo (like a fake medicine with no active ingredients) over three months. Within each group, people were further divided based on whether their thinking and memory were intact or mildly impaired. Researchers selected LGG due to its demonstrated potential benefits in previous animal studies.
The scientists discovered certain types of bacteria, like Prevotella ruminicola, Bacteroides thetaiotaomicron, and Bacteroides xylanisolvens, were more common in people with MCI. Most notably, they found that the Prevotella bacteria were significantly more common in people with MCI compared to those without it. Interestingly, when people with MCI took the LGG probiotics, the amount of Prevotella and another bacteria called Dehalobacterium in their guts decreased, and their cognitive scores improved. This suggests that probiotics could help improve thinking and memory abilities.
“The implication of this finding is quite exciting, as it means that modifying the gut microbiome through probiotics could potentially be a strategy to improve cognitive performance, particularly in individuals with mild cognitive impairment,” says Aljumaah. “This adds a new layer to our understanding of the microbiome brain-gut connection and opens up new avenues for combating cognitive decline associated with aging.”
‘New frontier in preventative strategies in cognitive health’
The findings also show that gut microbiome composition could serve as an early indicator for mild cognitive impairment, offering opportunities for earlier interventions to slow cognitive decline.
“By identifying specific shifts in the gut microbiome associated with mild cognitive impairment, we’re exploring a new frontier in preventive strategies in cognitive health,” concludes Aljumaah. “If these findings are replicated in future studies, it suggests the feasibility of using gut microbiome-targeted strategies as a novel approach to support cognitive health.”
The researchers are now investigating the specific mechanisms of how microbes like Prevotella influence the gut in a way that boosts brain health. Specifically, they are exploring how certain molecules produced by these bacteria can influence the functionality of neuroprotective hormones that cross the blood-brain barrier. If further studies confirm these results, these bacteria could be used as early signs of MCI, and by manipulating them with probiotics (like LGG), prebiotics (food for the “good” bacteria), and symbiotics (combination of probiotics and prebiotics), we might be able to support healthy brain aging.
Aljumaah, also affiliated with King Saud University in Saudi Arabia, presented these findings at NUTRITION 2023, an annual flagship meeting of the American Society for Nutrition taking place in Boston.







